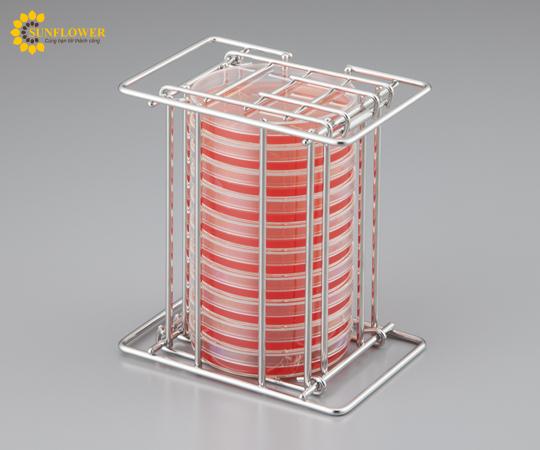

Cho phép lật ngược tất cả các đĩa petri lại với nhau khi đặt trên giá, sau đó đưa chúng vào lồng ấp.Nó sẽ cải thiện hiệu quả của việc kiểm tra vi khuẩn.
Được trang bị nắp đậy có thể đóng mở ở trên và dưới, cho phép lấy đĩa petri ra khỏi cả hai mặt.
Vật liệu: Thép không gỉ (SUS304)
Số ngăn chứa đĩa petri: 10 cái (Chiều cao đĩa petri: 15mm)
Đường kính đĩa petri thích ứng: φ90mm
Kích thước (mm): 145 x 100 x 157
Model: STS-10
Giá đựng đĩa Petri (loại úp ngược, thép không gỉ (SUS304), φ90 x 15mm, đựng 10 cái) AS ONE 2-4217-01 STS-10
Lồng đĩa Petri lật ngược giúp kiểm tra vi khuẩn dễ dàng hơn. Thiết kế nắp đậy mở ở cả hai mặt, từ trên và dưới, giúp tháo đĩa ra nhanh chóng. Sản phẩm được làm từ thép không gỉ SUS304, có số ngăn chứa đĩa petri linh hoạt.
Thông tin liên hệ
Vật Tư Sunflower đảm bảo 100% chất lượng của sản phẩm đúng như yêu cầu từ khách hàng và cung cấp đầy đủ MSDS, TDS, SDS cho từng sản phẩm. Nếu có nhu cầu mua sản phẩm Giá đựng đĩa Petri (loại úp ngược, thép không gỉ (SUS304), φ90 x 15mm, đựng 10 cái) AS ONE 2-4217-01 STS-10 hãy liên hệ đến Vật Tư Sunflower, chúng tôi sẽ hỗ trợ tư vấn nhiệt tình giúp bạn chọn được loại sản phẩm phù hợp.
Trên đây là những thông tin chi tiết về sản phẩm Giá đựng đĩa Petri (loại úp ngược, thép không gỉ (SUS304), φ90 x 15mm, đựng 10 cái) AS ONE 2-4217-01 STS-10 , để được tư vấn và báo giá về sản phẩm, xin vui lòng liên hệ lại ngay với Vật Tư Sunflower theo các thông tin sau:
Điện thoại: 0966068726 - 0937664495 (zalo)
Email: [email protected]
Website: https://vattusunflower.com
Địa chỉ: 4E Thất Khê, Minh Khai, Hồng Bàng, Hải Phòng